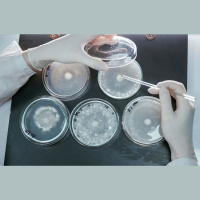

Synopsis
Populrzintnisks radiournls, kas aptver dadas zintnes nozares, izzina dabu, ekoloiju, eogrfiju, ornitoloiju, zooloiju, astronomiju, arheoloiju, vsturi, ielkojas zintnes un tehnikas sasniegumos, izcilu personbu dzv un darbb. paa uzmanba veltta latvieu zintnieku sasniegumiem pasaul un Latvij.aj informatvi izgltojoaj programm paredztas regulras rubrikas, piemram, interesanto un aktulo faktu mintes, Dienas jautjums klaustjiem, Ikona jeb ss ieskats kdas pardbas vai lietas izcelsm un vstur, k ar ststjums par noslpumainm un maz izzintm norism dab.Katr raidjum kop ar ptniekiem iztirzjam galveno tematu, uz sadarbbu aicinot ar savus klaustjus, vai k citdi uzklausot cilvku viedokus un jautjumus.
Episodes
-
Nākotnes lauksaimniecība: ko varēs ģenētiski modificēt, kādas šķirnes neizturēs stihijas
29/04/2025 Duration: 26minKlimata pārmaiņas draud ar lielākiem plūdiem, ilgstošākiem sausuma periodiem, negaidītām salnām un bez sniega ziemām. Šādiem apstākļiem tiek pielāgotas arī dažādu pārtikas augu kultūras. Ko var ģenētiski modificēt tā, lai tas būtu droši augam, videi un patērētajam, un kādu stihiju priekšā pat visizturīgākā šķirne ir bezspēcīga? Raidījumā Zināmais nezināmajā vērtē Latvijas Biomedicīnas pētījumu un studiju centra direktors, Latvijas Universitātes profesors Nils Rostoks un Latvijas Biozinātņu un tehnoloģiju universitātes Ekonomikas un sabiedrības attīstības fakultātes profesore Dina Popluga.
-
Bargas salnas nav nekas neparasts Latvijas pavasarim
29/04/2025 Duration: 24minAizvadītajā nedēļas nogalē Latvijā piedzīvojām itin bargas salnas. Nekas neparasts Latvijas pavasarim, bet ik gadu sāpīgi tiem, kas kaut ko audzē - vai tie būtu piemājas dārziņi vai plaši lauki, bet ir kultūras, kas cieš. Klimata pārmaiņas situāciju diemžēl ir padarījušas riskantāku. No vienas puses tas varētu šķist pretrunīgi - ja kopumā kļūst siltāks, kāpēc salnas varētu kļūt bīstamākas? Un nav pat runa par klimata pārmaiņu radītām straujākām laika svārstībām. Tādas pavasaros mums bijušas vienmēr. Taču tagad, ja uznāk siltums martā un aprīļa pirmajā pusē, tas ir krietni siltāks, nekā agrāk. Un pēdējos gados ir jau vairākkārt sasniegti iepriekš nepiedzīvoti siltuma viļņi tik agri pavasarī. Tas liek augiem pāragri attīstīties. Un ja viengadīgos augus mēs vēl varam paši kontrolēt - kad sēt, kad stādīt, tad ogulājus un augļukokus mēs nepierunāsim mazliet pagaidīt. Ja ir silts, tie sāk ziedēt, bet salnas, pat sasilstošā klimatā, tik drīz nepazudīs. Jau vēsturiski aukstuma viļņi aprīļa beigās un maijā ir bijuši
-
Vai dzīve laukos mūsdienās ir trūkuma vai luksusa simbols?
28/04/2025 Duration: 57minLielākā daļa Eiropas ir lauki un tieši lauku attīstībai un revitalizācijai iecerēts liels kongress Rīgā, kurā ar saviem pētījumiem pulcēsies pētnieki no 48 valstīm. Kā klājas lauku teritorijām pasaulē? Vai aizvien novērojama masveida migrācija uz pilsētām? Un, vai dzīve laukos mūsdienās ir trūkuma vai luksusa simbols? Raidījumā vērtē sociologs Miķelis Grīviņš, Rīgas Stradiņa universitātes tenūrprofesors. Vai mums ir tendence meklēt iespējas dzīvot laukos un tā jau ir tāda Luksus paradība - dzīvot laukos? Miķelis Grīviņš: Man liekas, ka tas ir komplekss fenomens, uz kuru nevar vienkārši atbildēt. Ja mēs mēģinām vienkāršu atbildi pateikt - nezinu, laukos tagad pēkšņi viss ir labi vai viss ir slikti, tad patiesībā mēs pazaudējam iespēju palīdzēt tām teritorijām, kurām varbūt ir grūti Neapšaubāmi, ir kaut kādas vietas, kas ir izbaudījušas to, ka parādās grupa, kura var atļauties un kuriem ir resursi, lai dzīvotu ārpus Rīgas. Te ir jāņem vērā, ka dzīve ārpus Rīgas paredz pilnīgi citus modeļus, pilnīgi citas inv
-
Statuss, nauda un prieka pēc - iemesli, kāpēc izvēlas studēt doktorantūrā
24/04/2025 Duration: 46minVairumam doktorantūras studijas un doktora grādu ieguvušie simbolizē akadēmiskus panākumus un saistās ar pētniecību un pasniedzēja darbu augstskolās, taču pieredze rāda, ka liela daļa doktorantūras studentu nemaz nesaista savu dzīvi ar zinātni. Vai doktora grāds var būt arī hobijs vai praktisks darbs sabiedrības labā? Ko īsti nozīmē studijas doktorantūrā un cik dažādi var būt doktorantūras virzieni, raidījumā Zināmais nezināmajā stāsta Latvijas Universitātes Doktorantūras skolas direktore, profesore Zanda Rubene, Latvijas Jauno Zinātnieku apvienības priekšsēdētājs, Elektronikas un datorzinātņu institūta pētnieks Oskars Teikmanis un Latvijas Kulturas akadēmijas 2. kursa doktorante Dita Šķēle. Oskars Teikmanis ikdienā nodarbojas ar robotiem un mašīnmācīšanos. Viņš strādā pie metodēm, kā iemācīt robotiem un citām līdzīgām ierīcēm kustēties visādos interesantos un noderīgos veidos. To viņš arī pēta doktorantūras ietvaros Dita Šķēle ikdienā strādā Latvijas dabas fondā, bet doktorantūrā studē Kultūras akadēmijā k
-
Iepazīstam pērtiķveidīgo dzīvnieku daudzveidību
23/04/2025 Duration: 51minAtliek uz mirkli pavērot pērtiķveidīgo dzīvnieku kustības, uzvedību, pat skatienu un uzreiz tik uzkrītošas līdzības varam saskatīt ar mums pašiem. Dzīvnieki, kas izpelnījušies titulu, kā visgudrākie un attīstītākie no dzīvniekiem, veido paši savas saziņas formas un vienlaikus spēj saprasties ar cilvēku. Iepazīstam to daudzveidību! Stāsta Rīgas Nacionālā Zooloģiskā dārza pārstāvis Māris Lielkalns. "Mēs, cilvēki, nenovērtējam pērtiķus. Re, kāds foršs, mīļš, jauks pērtiķītis, re, kāds viņš blēņdaris un tamlīdzīgi. Tad, kad viņš viņš pataisa vaļā zobus un parāda savus ilkņus, tad tiem, kas vairāk saprot no pērtiķiem, ļoti liela pārliecība rodas par pērtiķu spēku, par pērtiķu spējām aizstāvēties, par viņu ilkņu asumu," norāda Māris Lielkalns. Pērtiķi var būt ļoti bīstami. "Bet visu šo savu bīstamību un bīstamības ieročus viņi liek lietā tikai pašā pēdējā situācijā. Sākumā, ja ir iespējams, viņi vispirmām kārtām draud. Tas ir gan ciešs acu skatiens vai kaut kādas draudu pozas, arī māņu uzbrukums. Pērtiķis, lie
-
Ūdeņos nogrimušie dārgumi. Ko pēta zemūdens arheoloģija?
22/04/2025 Duration: 21minTo, vai jūras dzelme glabā zelta lādes un pirātu apslēptos dārgumus, diezin vai uzzināsim, taču jau šobrīd zināms, ka arī Baltijas jūrā un arī Latvijas iekšējos ūdeņos glabājas liecības no senas pagātnes. Ko pēta zemūdens arheologi? Ko slēpj upes Latvijā un mūsu Dzintara jūra? Raidījumā Zināmais nezināmajā skaidro arheologi - Latvijas Kultūras akadēmijas zinātniskais aistents Jānis Meinerts un Nacionālās kultūras mantojuma pārvaldes Arheoloģijas un vēstures daļas speciālists Kaspars Markuss Molls.
-
Golfa straumes iespējamā izzušana pētniekiem arvien ir ciets rieksts
22/04/2025 Duration: 24minJau gadu desmitiem runā, ka Ziemeļatlantijas jeb Golfa straume var apstāties un Eiropā tad sāktos ledus laikmets. Tomēr nav tik traki. Ziemeļatlantijas straume, kas silda Eiropu, biežāk tautā saukta par Golfa straumi, ir jau gadu desmitiem diskusiju objekts – tā apstāsies, palēnināsies, savārgs, izzudīs un ko tad mēs Eiropā darīsim? Sasalsim ragā? Pētniekiem šis ir ciets rieksts joprojām, bet pagaidām straume plūst kā plūdusi un silda Eiropu kā sildījusi. Starp citu pats nosaukums Golfa straume nav saistīts ar golfu, sporta spēli, bet gan ir fonētiski pārņemts, neiztulkojot no angļu valodas. Angliski to sauc Gulf stream un Gulf ir līcis, ar to domājot Meksikas līci, kur šī straume sākas. Pilnīgas skaidrības, kas ar straumi notiks nākotnē, nav, un tas rada lieliskus apstākļus dažnedažādām teorijām un pat sazvērestībām. Dažādas sazvērestības un spekulācijas rodas un arī zinātniekiem ir grūti noskaidrot patiesību par Golfa straumi, jo okeānu straumes un to ietekme uz laikapstākļiem un klimatu ir viena no vis
-
Lielie fizikas eksperimenti, kas imitē procesus visumā
17/04/2025 Duration: 45minRaidījumā Zināmais nezināmajā saruna par ļoti neparastiem eksperimentiem uz mūsu planētas. Cilvēkam nav lemts doties uz citu galaktiku, Visuma centru vai laika mašīnā novērot, kā radies kosmoss. Taču mēs to mērķtiecīgi darām tepat uz Zemes - eksperimentos, kuros cenšam rast atbildes uz jautājumiem, kuru atbildes meklējamas neiedomājami tālu vai sen. Kas ir šie eksperimenti? Kā mums sokas ar atbilžu meklējumiem, stāsta Kārlis Dreimanis, Rīgas Tehniskās universitātes Dabaszinātņu un tehnoloģiju fakultātes Daļiņu fizikas un paātrinātāju tehnoloģiju institūta direktors, un Andris Šternebrgs, Latvijas Universitātes Cietvielu fizikas institūta direktora vietnieks zinātnes jomā, fizikas doktors. Raidījuma noslēgumā zinātnes ziņas.
-
Plēsēji Latvijā: kā viņiem klājas un kā ar viņiem sadzīvot
16/04/2025 Duration: 50minNo ziemas miega modušies lāči, cilvēka tuvumā jau drošāk jūtas lūši, aizvien diskusijas par vilku sirojumiem lopkopju tuvumā. Kā klājas plēsējiem Latvijā? Ko zinām par šo dzīvnieku uzvedību un kā šīs zināšanas var palīdzēt sadzīvot ar Latvijas mežu iemītniekiem? Raidījumā Zināmais nezināmajā vērtē Latvijas Valsts mežu zinātnes institūta "Silava" pētnieks, zoologs Jānis Ozoliņš un šī paša institūta vadošā pētniece Guna Bagrade. Nesen plašsaziņas līdzekļos varējām lasīt informāciju par to, ka ASV zinātnieki pēc DNS paraugiem ir klonējuši pirms 10 tūkstošiem gadu izmirušu vilku sugu. Vai pēc pieejama fosilā ģenētiskā materiāla ir iespējams no jauna radīt sen izmirušas sugas, skaidro ģenētiķis Īzaks Rašals. Par savu izvēlēto zinātniskās fantastikas grāmatu stāsta astronomijas entuziaste, "StarSpace" observatorijas saimniece Anna Gintere. Viņa iepazīstina ar Daniela Suareza (Daniel Suarez) triloģijas pirmajām divām daļām "Delta-v" un "Critical Mass" (Kritiskā masa) "Grāmata zināmā mērā ieskicē to, ko varē
-
Satelīti: kādus labumus sniedz un riskus rada šie klusie novērotāji Zemes orbītā?
15/04/2025 Duration: 26minVirs mūsu galvām ikdienu pārvietojas teju 12 tūkstoši cilvēka radītu aparātu, kas ļauj mums izmantot digitālo tehnoloģiju labumus, prognozēt laikapstākļus un paredzēt stihiju sekas. Šo aparātu skaits strauji pieaug. Bet varbūt to jau ir par daudz? Kādus labumus un riskus mums sniedz šie klusie novērotāji Zemes orbītā? Raidījumā Zināmais nezināmajā analizē Vides risinājumu institūta vadošais pētnieks Dainis Jakovels un Latvijas Universitātes Ģoegrāfijas un zemes zinātņu fakultātes pētnieks Viesturs Zandersons.
-
Meteoroloģiskais radars: kā tas darbojas un kāpēc Latvijā ar to joprojām ir problēmas
15/04/2025 Duration: 22minTurpinām gatavoties sezonai, kad lietus mēdz uznākt pēkšņi, kopā ar negaisu un stihiskām parādībām – stirpu vēju vai krusu. Šīs parādības vislabāk iespējams novērot, novērtēt un pēc tam prognozēt ar meteoroloģiskā radara datiem. Kā tas darbojas un kāpēc Latvijā ar radaru mums joprojām ir problēmas? Vārds radars ir šīs tehnoloģijas nosaukuma saīsinātā vērsija. Tā gan ir tik plaši lietota, ka saīsinājums jeb abreviatūra ir kļuvusi par lietvārdu, bet patiesībā RADAR ir saīsināta angļu valodas frāze - "Radio Detecting And Ranging" - radio detektēšana un attāluma noteikšana. Diemžēl dažādas privātas meteoroloģiskās kompānijas, kas mūsdienās piedāvā laika prognožu lietotnes un interneta vietnes, šo terminu ir sabojājušas un raisījumas apjukumucilvēku galvās. Bieži nākas saņemt no cilvēkiem ekrānšaviņus ar kādām laika prognožu kartēm, ko viņi lieto telefonā vai datorā, un lai kāds būtu jautājums, tas bieži sākas: "šajā radara kartē rādā to un to, piemēram, ka ārā jābūt +10 grādiem, bet patiesībā ir +15, vai rādīja
-
Neparastā Sibīrijas vulkāniskā sistēma un vulkānu aktivitāte Eiropā
14/04/2025 Duration: 51minPēc klausītāju lūguma skaidrojam, kāda bijusi vulkāniskā aktivitāte Latvijas tuvumā, sākot ar vulkāniem tepat Viduseiropā, beidzot ar Sibīrijas neparasto vulkānisko sistēmu. Klausītāja lūgums mudināja mūs aizdomāties par to, kur vēl Eirāzijas ziemeļos un Eiropā varam manīt senas vulkāniskās aktivitātes liecības. Vai šie simtiem miljonu gadu vecie vulkāni Sibīrijā vainojami masveida izmiršanā uz mūsu planētas un kā tik senu vēsturi var izšķetināt raugoties Eirāzijas kalnu sistēmās šodien? Raidījumā Zināmais nezināmajā skaidro Latvijas Universitātes Eksakto zinātņu un tehnoloģiju fakultātes asociētais profesors, ģeogrāfs Ivars Strautnieks un Latvijas Universitātes Eksakto zinātņu un tehnoloģiju fakultātes asociētais profesors, ģeologs Ģirts Stinkulis. Bioogles – skats no ķīmiķa darba ikdienas skatpunkta Iestājoties siltam laikam, noteikti aizvien iecienītāki kļūs arī dažādi dārza svētki un maltīšu gatavošana, tostarp grilēšana. Un kur grilēšana, tur bieži vien līdzās ir kokogles, lai maltīti pagatavotu. Mēs š
-
Īpašā pārtika - ceļojumiem, krīzēm, arī karam
10/04/2025 Duration: 40minUzturs, kuru ikdienā servējam sev uz šķīvja, krietni atšķiras no tā, ko cilvēki ēd apstākļos, kur nav ne virtuves rīku, iekārtu, ne ledusskapju. Un tomēr kalnos kāpējiem, karavīriem un ikvienam, kam ilgstoši jābūt dabā un kustībā, nepieciešams bagātīgs uzturs. Te lieti noder pārtikas tehnologu ieviestie risinājumi, kas ļauj ar ilgu derīguma termiņu, bagātīgu uzturvētību un mazu apjomu sagatavot pārtiku dažādām situācijām. Kā to pārveidot tā, lai to var viegli lietot un pārnēsāt un vienlaikus, lai tas nezaudē savu vērtību? Skaidro Latvijas Biozinātņu un tehnoloģiju universitātes profesore un Tehnoloģiju un zināšanu pārneses nodaļas vadītāja Sandra Muižniece-Brasava un šīs universitātes Pārtikas institūta vadošā pētniece, docente Asnate Ķirse-Ozoliņa. Raidījuma noslēgumā Zinātnes ziņas Vienojošais vārds šīs dienas zinātnes ziņām varētu būt “retumi”, kas ieraudzīti pirmo reizi vai arī otrādi - kas ilgu laiku nav redzēti un pārsteidz no jauna, vai arī kurus cilvēki paši mēģina radīt no jauna. Vai zinātnieki pa
-
Bērnības izpratne agrāk un tagad
09/04/2025 Duration: 49minBērnība, kādu šodien izdzīvo bērni rietumu pasaulē, ir krietni atšķirīga no tās, kuru piedzīvoja paaudzes pirms tam. Ne velti mēs nereti kavējamies nostaļģiskās atmiņās par savu bērnību, spriežot par to, cik pareizas vai nepareizas bērnības piedzīvo mūsdienu bērni. Kāda bija bērnu dzīve senāk? Kad radās izpratne par bērnu attīstību un kad sabiedrība sāka izjust nepieciešamību radīt jaunu sistēmu, pielāgotu bērnu vajadzībām? Raidījumā Zināmais nezināmajā diskutē Latvijas Universitāes (LU) Izglītības zinātņu un psiholoģijas fakultātes profesore, gramatas "Digitala berniba" autore Zanda Rubene, vēsturnieks, LU profesors Gvido Straube un Latvijas Bērnu labklājības tīkla politikas koordinatore Evisa Stankus. Profesors: Veselīgai ģimenes videi ir būtiska nozīme bērna attīstībā Nesen Latvijā viesojās viens no zināmāmakjiem bērnu attīstības psihologiem pasaulē – Upsālas universitātes profesors Gustafs Gredebeks. Sarunā viņš stāsta par bērna sociālo, emocionālo un izziņas attīstību agrīnā vecumā un skaidro, kāpē
-
Kā mēra, modelē un plāno trokšņu piesārņojumu pilsētvidē?
08/04/2025 Duration: 27minDzīvojam skaļā gadsimtā, kad apkārtējās vides trokšņi teju diennakts garumā skan fonā mūsu ikdienas darbībām. Īpaši to novērojam pilsētā, kur transports, būvniecība un sadzīves skaņas bieži laužas ēkās pat caur aizvērtiem logiem. Kā mēra, modelē un plāno trokšņu piesārņojumu pilsētvidē un ar ko atšķiras trokšņi ūdenī no trokšņiem uz sauszemes? Raidījumā Zināmais nezināmajā skaidro ģeogrāfijas zinātņu doktore, Latvijas Universitātes Eksakto zinātņu un tehnoloģiju fakultātes profesore Iveta Šteinberga un Latvijas Hidroekoloģijas institūta Jūras monitoringa nodaļas pētnieks Māris Skudra un Veselības inspekcijas Vides veselības nodaļas vadītājs Normunds Kadiķis.
-
Negaisu sezona tuvojas: kā darbojas izlāžu kartes dažādās lietotnēs
08/04/2025 Duration: 21minŠajā sezonā Latvijā vēl nav bijis pirmais pavasarīgais negaiss, lai arī pēdējos gados tie ir bijuši gan marta beigās, gan aprīļa sākumā. Bet negaisu sezona nav aiz kalniem, tāpēc raidījumā stāsts par rīku, ko ikdienā jau vismaz 10-15 gadus izmanto daudzi cilvēki - tie ir zibens sensoru dati, kartes dažādās lietotnēs un interneta vietnēs, kur reālā laikā varam redzēt, kur ir bijusi zibens izlāde. Kā šādi rīki darbojas un uzticami ir šie dati? Viens no veidiem, kā negaisa dienā uzzināt, vai zibeņošana tuvojas, ir skatīties zibens izlāžu kartes. Tās ir brīvi pieejamas dažādās lietotnēs un interneta vietnēs, un dati par katru zibens izlādi tur parādās burtiski dažas sekundes pēc tam, kad zibens ir uzplaiksnījis. Kā tiek noteikts, ka zibens ir bijis un kur tas ir bijis, skaidro Latvijas Vides, ģeoloģijas un meteoroloģijas centra datu analītiķis Raitis Sondors. Princips no vienas puses nav sarežģīts. Vecākas paaudzes cilvēki noteikti atminas, ka tad, kad radio raidīja AM viļņos, negaisa laikā, kad nozibeņo, ra
-
Jaunākie cietvielu fizikas pētījumi Latvijā
07/04/2025 Duration: 50minLatvijā noslēdzies viens no lielākajiem zinātnes projektiem, kas ilga astoņus gadus un nesis dažādus jaunievedumus un atklājumus cietvielu fizikā. Daži no tiem ļaus precīzāk mērīt gaisa un ūdens kvalitāti, citi - veidot orgānus uz čipa vai plašāk izmantot lāzertehnoloģijas. Par pētījumiem stāsta fiziķis, Latvijas Universitātes Cietvielu fizikas institūta direktors Andris Anspoks un fiziķis, Latvijas Universitātes Cietvielu fizikas institūta direktora vietnieks zinātnes jomā Andris Šternbergs. Projekta ietvaros izstrādāta arī ūdens kvalitātes mērījumu iekārta. Kā paildzināt bateriju mūžu un kā panākt, ka tās uzglabā vairāk enerģijas? Ar šādu pētījumu nodarbojas Latvijas Universitātes Cietvielu fizikas institūta enerģijas materiālu laboratorijā. Par pētījumu stāsta laboratorijas vadītājs Gints Kučinskis, savukārt sižeta autore Zane Lāce-Baltalksne izmēģināja līdz pleciem garos gumijas cimdos darboties noslēgtā kastē, kas pildīta ar argona gāzi. LU Cietvielu fizikas institūta enerģijas materiālu laborat
-
Bakteriofāgi: kas par šiem organismiem izpētīts Latvijā un kā tie var palīdzēt
02/04/2025 Duration: 53minAntibiotiku patēriņš pasaulē pieaug, līdz ar to pieaug arī rezistence pret šiem medikamentiem. Dažkārt tas var draudēt ar nopietnām briesmām cilvēka veselībai un dzīvībai. Taču ne visi vīrusi ir kaitīgi, daži palīdz ārstiem uzveikt bīstamas baktēriju infekcijas. Tos dēvē par bakteriofāgiem - vīrusi, kuri nevēlamo baktēriju neitralizē. Kas par šiem organismiem atklāts un izpētīts Latvijā un kā fāgu terapija varētu palīdzēt pacientiem šodien un nākotnē? Raidījumā Zināmais nezināmajā skaidro Rīgas Stradiņa universitātes profesore, Bioloģijas un mikrobioloģijas katedras vadītāja un Sabiedrības veselības institūta vadītāja Juta Kroiča nefrologs, Rīgas Stradiņa universitātes zinātņu prodekāns un fāgu pētnieks Kārlis Rācenis. "Rezistences problēma ir arvien biedējošāka un ir jādomā par alternatīvām ārstēšanas metodēm un bakteriofāgs ir viens no tādiem," atzīst Juta Kroiča. Diemžēl kara periodi ir tik, kad "fāgus" izmanto arvien vairāk. Tos atklāja Pirmā pasaules kara laikā, kad daudzas dzīvības glāba, tos plaši iz
-
Ko augiem sniedz pavasaris ar cīruļputeņiem, salnām, pēkšņu karstumu un ilgu sausumu
01/04/2025 Duration: 27minIlgi gaidītais pavasaris daudziem saistās vai nu ar patikamo sajūtu, ka beidzot varam saulītē baudīt siltumu un ieelpot svaigumu, vai arī ar tā saukto pavasara nogurumu un vitamīnu trukumu. Interesanti, kāds šis laiks ir pašai dabai? Vai arī augiem jāsteidz uzņemt spēki pēc garās ziemas vai gluži pretēji - tie spēkpilni steidz augt un ziedēt, lai gādātu vēlāk augļus? Ko augiem mūsu dārzos un savvaļā sniedz pavasaris ar cīruļputeņiem, salnām, pēkšņu karstumu un ilgu sausumu? Raidījumā Zināmais nezināmajā skaidro Latvijas Universitātes Medicīnas un dzīvības zinātņu fakultātes Augu fizioloģijas katedras vadītājs, profesors Ģederts Ieviņš un Latvijas Universitātes Medicīnas un dzīvības zinātņu fakultātes vadošā pētniece Olga Sozinova.
-
Aprīlis - laikapstākļu ziņā nešpetns mēnesis
01/04/2025 Duration: 23minAprīlis ir laiks, kad arī pacietīgākie un prātīgākie pavasara gaidītāji bieži uzķeras - uznāk siltums, sāk sēt un stādīt, tad seko sniegs un sals, pārdzīvojumi par to, vai sastrādātais neaizies bojā, sargāšana no salnām ar segšanu, dūmošanu un vēl visām metodēm. Aprīli var uzskatīt laikapstākļu ziņā par kontrastiem bagātāko mēnesi. Aprīlī var būt var vasarīgs siltums un pat tveice, var būt arī sniegs un sals, un pat tāds sniegs, ka var mierīgi slēpot. Būtiski, kādā secībā šādi laikapstākļi nāk - ja pusmetrīgam sniegam seko vasarīga tveice, tad viss ir kārtībā. Tāpēc jau aprīlis ir tik ļoti nešpetns, ka tas miksē laikapstākļus dažādā secībā. Šoreiz atskatāmies ekstremālākos laikapstākļu notikumos, ko aprīlis mums nesis. Piemēram, 2001. gadā aprīļa sākumā bija pat līdz 19 grādiem silts, bija arī ļoti sauss un 9. aprīļa "Panorāmā" bija sižets par neparasti agriem un plašiem mežu ugunsgrēkiem, par kuriem ugunsdzēsēji norādīja, ka tie visi ir cilvēku radīti. 2001. gadā pēc gandrīz vasarīga aprīļa sākuma, ka